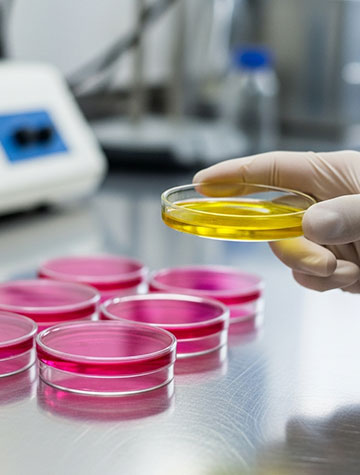

A oncologia exige precisão e excelência, e na Insuma, oferecemos suporte essencial para garantir que esses padrões sejam cumpridos.
Nossa expertise na manipulação de formulações específicas assegura a segurança e eficácia necessárias para atender às rigorosas demandas.
A Quimioterapia consiste na utilização de medicamentos específicos que podem ser administrados por diversas vias, sendo a mais comum a via endovenosa, como objetivo destruir células tumorais através de mecanismos que interferem no ciclo celular. A manipulação de medicamentos quimioterápicos oferece precisão e segurança na personalização através da miligramagem e diluição das drogas que serão administradas no paciente.
Seguimos com rigor os critérios de Boas Práticas de Manipulações Magistrais conforme RDC 220/2004, o que garante a produção de bolsas de quimioterapia dentro dos altos padrões de qualidade e segurança, desde a análise da prescrição ao manuseio da matéria-prima até o produto final.

Suporte técnico realizado por farmacêuticos clínicos especializados;
Todos os medicamentos disponibilizados no mercado para realização do processo terapêutico indicado.
Expertise logística no atendimento;
A infusão de soluções contendo anticorpos monoclonais (alvo-específicos), conhecida como imunoterapia, é um tratamento seguro e eficaz que ganha cada vez mais espaço para tratamento de neoplasias e outras condições clínicas importantes, como a psoríase, artrite reumatóide e doença de Crohn.
Suporte técnico realizado por farmacêuticos clínicos especializados;
Todos os medicamentos disponibilizados no mercado para realização do processo terapêutico indicado.
Expertise logística no atendimento;
Oferecemos um serviço especializado de manipulação de bolsas para tratamento hematológico, atendendo às necessidades de hospitais e clínicas com excelência e segurança. Combinamos tecnologia de ponta e rigorosos padrões de qualidade para fornecer soluções estéreis personalizadas, garantindo a eficácia e a segurança dos tratamentos hematológicos.
Nosso processo de manipulação é personalizado de acordo com as necessidades específicas de cada paciente, garantindo que cada bolsa contenha a dosagem exata dos medicamentos prescritos.
Oferecemos serviço especializado nas manipulações dos medicamentos imunobiológicos miligramados, utilizados no tratamento de doenças inflamatórias, autoimunes, degenerativas ou genéticas que além de afetarem ossos, ligamentos, músculos ou tendões também podem atingir como coração, olhos, pele e pulmões.
Medicamentos de Alta Vigilância (MAV) são aqueles que apresentam alto risco de provocar danos significativos aos pacientes se houverem falhas em sua utilização, como as soluções eletrolíticas, em especial aquelas contendo potássio. A manipulação à beira leito de eletrólitos concentrados representa um ponto crítico na jornada do medicamento e requer controles rigorosos para redução de riscos.
A padronização de soluções prontas para uso, formuladas de acordo com prescrição médica, aumenta exponencialmente a segurança do paciente, eliminando pontos potencialmente vulneráveis nos processos que envolvem a prescrição, manipulação e administração desses medicamentos na rotina hospitalar.
A Medicina Nuclear é uma especialidade que utiliza energia nuclear, através da administração de radiofármacos, no diagnóstico e tratamento de doenças.
Oferecemos a manipulação de soluções para suporte em terapias de medicina nuclear, incluindo soluções contendo aminoácidos nefroprotetores para terapias que utilizem lutécio 177Lu.
A neurologia exige tratamentos altamente especializados, especialmente em condições complexas como a Esclerose Múltipla. Com isso, buscamos simplificar o trabalho de clínicas e hospitais ao fornecer bolsas de infusão personalizadas, prontas para uso e entregues no momento exato. Nosso serviço existe para descomplicar a logística e garantir que cada tratamento neurológico seja administrado com a máxima segurança e precisão, permitindo que os profissionais de saúde se concentrem no que realmente importa: o cuidado com o paciente.
No tratamento de doenças raras, unimos nossa expertise em manipulação de soluções infusionais à tecnologia de ponta para fornecer um suporte completo a clínicas e hospitais. Cuidamos de todo o processo de aquisição e preparo dos medicamentos, entregando bolsas de infusão personalizadas, prontas para uso, e no momento exato em que são necessárias. Assim, garantimos máxima segurança, precisão e praticidade, permitindo que cada paciente receba o tratamento adequado de forma eficiente e sem preocupações.
Na área de gastroenterologia, nosso compromisso vai além da simples entrega de medicamentos. Combinamos nossa expertise em manipulação de soluções infusionais com tecnologia avançada para atender às demandas complexas desse campo, que abrange desde doenças inflamatórias intestinais até tratamentos de suporte nutricional.
Oferecemos um suporte integral a clínicas e hospitais, cuidando de todo o processo de aquisição e preparo dos medicamentos. As bolsas de infusão que fornecemos são personalizadas de acordo com as necessidades específicas de cada paciente, garantindo que os tratamentos sejam administrados com máxima segurança e eficácia.
Oferecemos um serviço especializado de manipulação de bolsas para tratamento hematológico, atendendo às necessidades de hospitais e clínicas com excelência e segurança. Combinamos tecnologia de ponta e rigorosos padrões de qualidade para fornecer soluções estéreis personalizadas, garantindo a eficácia e a segurança dos tratamentos hematológicos.
Nosso processo de manipulação é personalizado de acordo com as necessidades específicas de cada paciente, garantindo que cada bolsa contenha a dosagem exata dos medicamentos prescritos.
Oferecemos serviço especializado nas manipulações dos medicamentos imunobiológicos miligramados, utilizados no tratamento de doenças inflamatórias, autoimunes, degenerativas ou genéticas que além de afetarem ossos, ligamentos, músculos ou tendões também podem atingir como coração, olhos, pele e pulmões.
Medicamentos de Alta Vigilância (MAV) são aqueles que apresentam alto risco de provocar danos significativos aos pacientes se houverem falhas em sua utilização, como as soluções eletrolíticas, em especial aquelas contendo potássio. A manipulação à beira leito de eletrólitos concentrados representa um ponto crítico na jornada do medicamento e requer controles rigorosos para redução de riscos.
A padronização de soluções prontas para uso, formuladas de acordo com prescrição médica, aumenta exponencialmente a segurança do paciente, eliminando pontos potencialmente vulneráveis nos processos que envolvem a prescrição, manipulação e administração desses medicamentos na rotina hospitalar.
A Medicina Nuclear é uma especialidade que utiliza energia nuclear, através da administração de radiofármacos, no diagnóstico e tratamento de doenças.
Oferecemos a manipulação de soluções para suporte em terapias de medicina nuclear, incluindo soluções contendo aminoácidos nefroprotetores para terapias que utilizem lutécio 177Lu.
A neurologia exige tratamentos altamente especializados, especialmente em condições complexas como a Esclerose Múltipla. Com isso, buscamos simplificar o trabalho de clínicas e hospitais ao fornecer bolsas de infusão personalizadas, prontas para uso e entregues no momento exato. Nosso serviço existe para descomplicar a logística e garantir que cada tratamento neurológico seja administrado com a máxima segurança e precisão, permitindo que os profissionais de saúde se concentrem no que realmente importa: o cuidado com o paciente.
No tratamento de doenças raras, unimos nossa expertise em manipulação de soluções infusionais à tecnologia de ponta para fornecer um suporte completo a clínicas e hospitais. Cuidamos de todo o processo de aquisição e preparo dos medicamentos, entregando bolsas de infusão personalizadas, prontas para uso, e no momento exato em que são necessárias. Assim, garantimos máxima segurança, precisão e praticidade, permitindo que cada paciente receba o tratamento adequado de forma eficiente e sem preocupações.
Na área de gastroenterologia, nosso compromisso vai além da simples entrega de medicamentos. Combinamos nossa expertise em manipulação de soluções infusionais com tecnologia avançada para atender às demandas complexas desse campo, que abrange desde doenças inflamatórias intestinais até tratamentos de suporte nutricional.
Oferecemos um suporte integral a clínicas e hospitais, cuidando de todo o processo de aquisição e preparo dos medicamentos. As bolsas de infusão que fornecemos são personalizadas de acordo com as necessidades específicas de cada paciente, garantindo que os tratamentos sejam administrados com máxima segurança e eficácia.